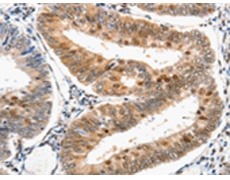
一抗

|
Background: |
The protein encoded by this gene is the large subunit (p127) of the heterodimeric DNA damage-binding (DDB) complex while another protein (p48) forms the small subunit. This protein complex functions in nucleotide-excision repair and binds to DNA following UV damage. Defective activity of this complex causes the repair defect in patients with xeroderma pigmentosum complementation group E (XPE) - an autosomal recessive disorder characterized by photosensitivity and early onset of carcinomas. However, it remains for mutation analysis to demonstrate whether the defect in XPE patients is in this gene or the gene encoding the small subunit. In addition, Best vitelliform mascular dystrophy is mapped to the same region as this gene on 11q, but no sequence alternations of this gene are demonstrated in Best disease patients. The protein encoded by this gene also functions as an adaptor molecule for the cullin 4 (CUL4) ubiquitin E3 ligase complex by facilitating the binding of substrates to this complex and the ubiquitination of proteins. |
|
Applications: |
ELISA, WB, IHC |
|
Name of antibody: |
DDB1 |
|
Immunogen: |
Synthetic peptide of human DDB1 |
|
Full name: |
DNA damage-binding protein 1 |
|
Synonyms: |
XPE, DDBA, XAP1, XPCE, XPE-BF, UV-DDB1 |
|
SwissProt: |
Q16531 |
|
ELISA Recommended dilution: |
500-5000 |
|
IHC positive control: |
Human cervical cancer |
|
IHC Recommend dilution: |
25-100 |
|
WB Predicted band size: |
127 kDa |
|
WB Positive control: |
Human fetal small intestine, liver cancer and Lymphoma, 293T and A549 cells |
|
WB Recommended dilution: |
200-500 |


 購物車
購物車 幫助
幫助
 021-54845833/15800441009
021-54845833/15800441009